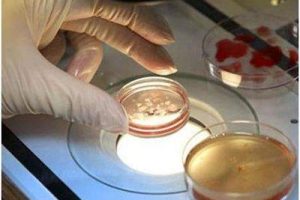

试管婴儿男性精子采集的完整流程科普:准爸爸必看指南
试管婴儿(也称为体外受精-胚胎移植技术)是一种辅助生殖技术,通过在实验室环境中将精子和卵子结合形成胚胎,然后将其移植到女性子宫内。在这个过程中,精子的提取和卵子的提取是两个重要的步骤,通常会安排在同一天进行。许多准爸爸希望提前了解相关流程以缓解紧张情绪,以下是关于精子提取的详细指南:
1.初期调理阶段(治疗周期的前三到六个月)
此阶段的目标是提升精子质量,为后续的受精过程做好准备。
- 必须严格戒烟戒酒,因为烟酒会损害精子DNA的完整性,降低其活力。此外,还要避免熬夜,因为熬夜会影响内分泌的稳定,干扰精子的生成规律。
- 保持均衡的饮食(多摄入富含锌、硒和维生素的食物,如坚果和深海鱼),并进行适量的运动(避免高强度训练),以维持健康的体重。
- 如果出现前列腺炎、附睾炎等生殖系统炎症,应及时进行治疗(这些炎症可能导致精子畸形率增加或活力降低)。
2.禁欲调整期(治疗阶段内)
女性月经周期的第8天开始,男性需要遵循以下步骤:
- 首先进行一次精液排放,然后将精液送到实验室进行常规检查(评估精子的数量、活力和形态)。
- 接下来进入禁欲期(不进行性生活或手淫射精),直到取卵日。
关键提示:禁欲时间应控制在3到7天之间——如果时间过短,(7天)会影响精子的活力和存活率,具体情况请遵循医生的建议。
3.药物辅助阶段(按医嘱进行)
部分男性在医生的指导下可能需要服用药物,以预防感染或调节免疫状态。
- 泼尼松:常用于调节免疫相关的问题。具体的剂量(例如早上服用半片或下午服用一片)应由医生根据个人情况来确定,请勿自行调整。需服用至取卵当天。
- 诺氟沙星:短期使用(3-5天)以防止生殖系统感染。
4.取卵术前准备(取卵当天)
男士到达生殖中心后,需要完成以下几个步骤:
- 用肥皂认真洗手,并将手擦干。
- 进入私密取精室后,首先需要核对取精杯上的夫妻姓名,以避免样本混淆。
- 请使用中心提供的无菌盐水棉球擦拭外生殖器(请勿使用日常肥皂,以免影响精子活性);
- 使用无菌纱布轻轻擦干双手及外生殖器,以防水分或杂质污染样本。
5.精子收集过程
- 常规取精使用一次性无菌取精杯采集时,请注意以下事项:①不要接触杯口、内壁和底部;②避免阴毛和衣物纤维掉入杯中;③如果杯内有异物,需立即告知医护人员以更换杯子;④采集后请及时盖好杯盖并提交给实验室。
- 特殊情况下取精。如果有射精困难或无精子症的情况,需要通过睾丸穿刺(微创手术,局部麻醉下获取睾丸组织内的精子)或附睾穿刺(提取附睾内的精子)来获取精子。这类手术疼痛感较轻,一般在手术后1到2天内即可恢复。
- 冷冻/精子储存用途如果提前冷冻了精子或使用供精,实验室会直接进行解冻供备用,男方当天不需要进行采集。
与温馨提示
尽管精子采集操作相对简单,但每一个环节都直接关系到精子质量,而精子质量是胚胎形成和成功着床的关键因素之一。准备成为父亲的男性应严格按照流程进行,如有任何疑问(例如感到紧张或操作不顺),请及时与医务人员进行沟通。
注意:本文内容为一般性指南,具体流程应根据就诊生殖中心提供的个性化方案进行调整。
医院 · 516多所试管婴儿医院
医生 · 2497位试管婴儿医生
同龄 · 100万姐妹试管好孕群